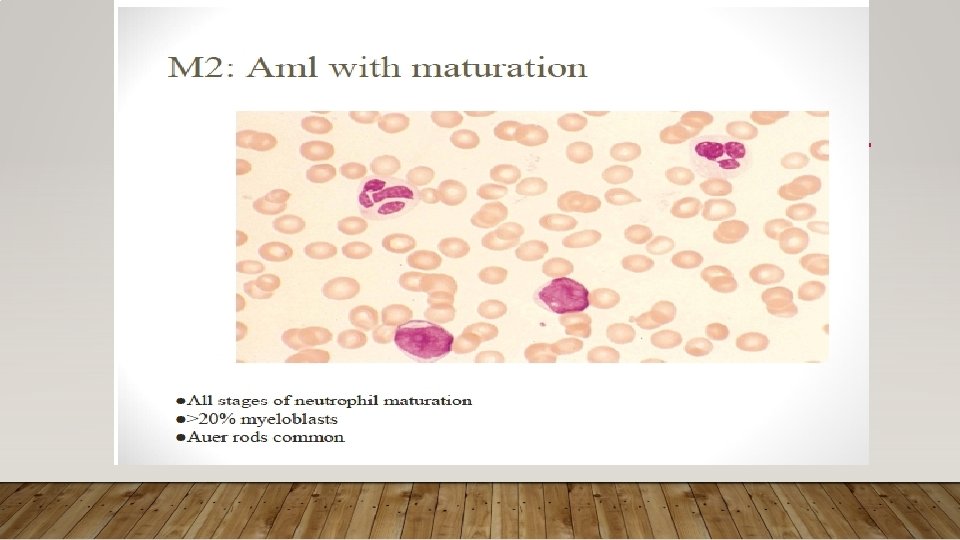
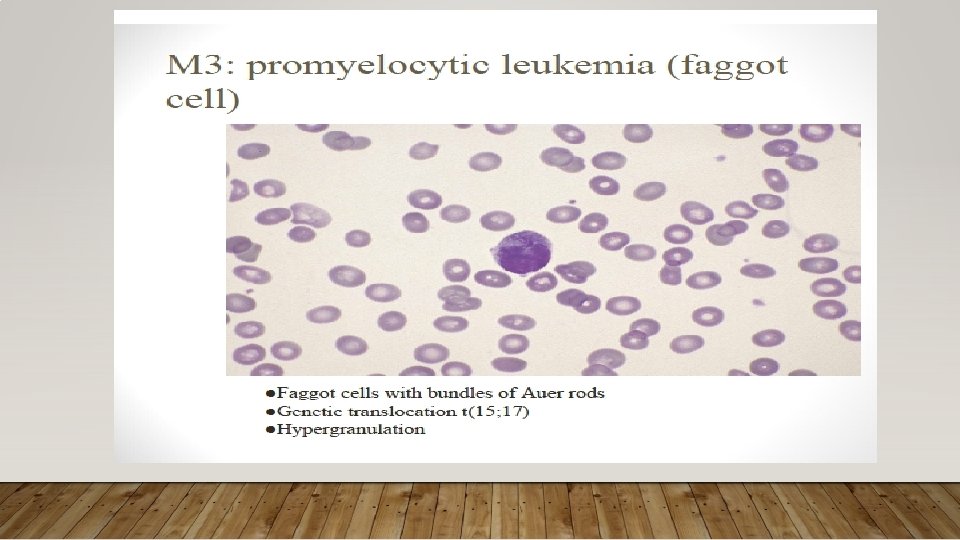
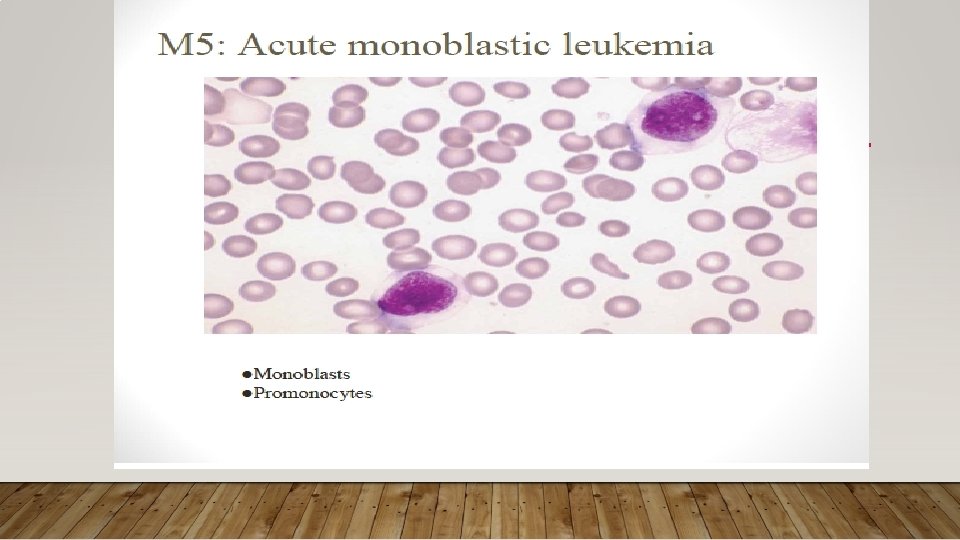

CLASSIFICATION OF AML PROGNOSTIC FACTORS HOW IS ACUTE

- Slides: 53
CLASSIFICATION OF AML & PROGNOSTIC FACTORS
HOW IS ACUTE MYELOID LEUKEMIA CLASSIFIED? • Although the first published reports of leukemia occurred in 1845 by Bennett and Virchow, the lack of refined diagnostic methodology limited the distinction between myeloid and lymphoid acute leukemia, With the development of refined staining techniques, followed by microscopy and histochemical staining by the mid-20 th century, this distinction was possible
HOW IS ACUTE MYELOID LEUKEMIA CLASSIFIED? • Historically, AML was classified by the morphology and cytochemical (and later flow cytometric) phenotype of the tumor cells under the French-American-British (FAB) AML classification system. (in 1976 and later revised in 1985) • FAB system divided AML into subtypes, M 0 through M 7, based on the type of cell from which the leukemia develops and how mature the cells are. This was based largely on how the leukemia cells looked under the microscope after routine staining
• The FAB classification system is useful and is still commonly used to group AML into subtypes. • It is very useful, particularly in its recognition of acute promyelocytic leukemia (AML FAB M 3) as a distinct entity. • But it doesn’t take into account many of the factors that are now known to affect prognosis.
• The classification of AML has changed dramatically over the course of the last several decades, and perhaps more than in any other group of malignancies, the classification of AML is now predicated on identifying the genetic aberrations underlying an individual patient’s disease • The purpose of AML classification and genetic testing at diagnosis is largely to risk-stratify patients with AML, and thus help determine appropriate treatment modalities.
• The World Health Organization (WHO) has developed a newer system that includes some of these factors to try to better classify AML(1997, 2001) • WHO classification of AML has since moved toward a system based more on underlying genetics, first incorporating recurrent structural cytogenetic abnormalities, then specific gene mutations in the most recent 2008 edition
• In 2008, the WHO criteria were revised and included additional entries in the category of AML with recurrent genetic abnormalities. • One important revision was to modify "AML with abnormalities of l 1 q 23; MLL" from the previous edition and to change this to t(9; 1 l)(p 22; q 23); MLLT 3 -MLL. • This was done to reflect that all MLL rearrangements are not identical. In fact, it is recommended that variant MLL translocations also be specified in the diagnosis. • Additional chromosomal rearrangements added to the most recent WHO classification include t( 6; 9)(p 23; q 34); DEK-NUP 21, inv(3)(q 21 q 26. 2) or t(3; 3)(q 26. 2); RPN 1 -EVll, and t(1; 22)(p 13; q 13); RBM 15 -MKLl
AML WITH RECURRENT GENETIC ABNORMALITIES • Minor refinements related to updates in gene names (such as the change from MLL to KMT 2 A) are included • as well as recognition that the inv(3)(q 21. 3 q 26. 2) or t(3; 3)(q 21. 3; q 26. 2) does not represent a fusion gene, but repositions a distal GATA 2 enhancer to activate MECOM expression and simultaneously confer GATA 2 haploinsufficiency.
• In order to stress the significance of the PML-RARA fusion, which may be cryptic or result from complex cytogenetic rearrangements other than t(15; 17)(q 24. 1; q 21. 2), acute promyelocytic leukemia (APL) with this fusion is renamed as APLwith PMLRARA. • Finally, a new provisional category of AML with BCR-ABL 1 is added to recognize these rare de novo AML cases that may benefit from TKI therapy. • Although the diagnostic distinction between de novo AML with BCR-ABL 1 and blast transformation of CML may be difficult without adequate clinical information, the significance of detecting this targetable fusion is felt to warrant a provisional disease category. • Preliminary data suggest that deletion of antigen receptor genes (IGH, TCR), IKZF 1 and/or CDKN 2 A may support a diagnosis of de novo disease vs BP of CML.
• The finding that the improved prognosis associated with AML with mutated CEBPA is associated with biallelic, but not single • Additionally, due to the lack of prognostic significance of multilineage dysplasia in patients without MDS-associated cytogenetic findings and with a mutation of NPM 1 or biallelic mutation of CEBPA, these mutations now supersede the presence of multilineage dysplasia in the classification.
• Finally, a provisional category of AML with mutated RUNX 1 has been added to the classification for cases of de novo AML with this mutation that are not associated with MDS-related cytogenetic abnormalities. • This new provisional disease category appears to represent a biologically distinct group with a possibly worse prognosis than other AML types.
AML WITH MYELODYSPLASIA-RELATED CHANGES • The presence of multilineage dysplasia alone will not classify a case as AML with myelodysplasia-related changes when amutation of NPM 1 or biallelic mutation of CEBPA is present. • In cases lacking these mutations, the morphologic detection of multilineage dysplasia (defined as the presence of 50%or more dysplastic cells in at least 2 cell lines) remains a poor prognostic indicator and is sufficient to make a diagnosis of AML with myelodysplasia-related changes. • A history of MDS remains as an inclusion criterion for this category as does the presence of an MDS-related cytogenetic abnormality with 1 exception: del(9 q) has been removed as a defining cytogenetic abnormality for. AMLwith myelodysplasiarelated changes because of its association with NPM 1 or biallelic CEBPA mutations
THERAPY-RELATED MYELOID NEOPLASMS • Therapy-relatedmyeloid neoplasms (t-MNs) remain as a distinct category in the classification for patients who develop myeloid neoplasms following cytotoxic therapy. • The t-MNs may be further subdivided as therapy-related MDS or AML (t-MDS or t -AML), but the associated cytogenetic abnormality, which is important for determining therapy and prognosis, should be identified in the final diagnosis. • A number of t-MN cases have been shown to have germ line mutations in cancer susceptibility genes; careful family histories to uncover cancer susceptibility are warranted in t-MN patients
AML, NOT OTHERWISE SPECIFIED • Although the subcategories of AML, not otherwise specified (NOS) lack prognostic significance when cases are classified based on NPM 1 mutation and CEBPA biallelic mutation status, the CAC agreed to keep the AML, NOS subcategories with only a single change: • The subcategory of acute erythroid leukemia, erythroid/myeloid type(previously defined as a case with >50% BM erythroid precursors and >20% myeloblasts among nonerythroid cells) has been removed from the AML category. • In the new classification, myeloblasts are always counted as a percentage of total marrow cells and the majority of such cases have<20% total blast cells and are now classified as MDS (usually MDS with excess blasts).
• Cases with 50% or more erythroid cells and >20% total myeloblasts usually meet criteria for AML with myelodysplasia-related changes and should be diagnosed as such; cases with>20% total myeloblasts not meeting criteria for AML with myelodysplasia-related changes or AML with recurrent genetic abnormalities should be categorized as 1 of the other subtypes of AML, NOS. • Pure erythroid leukemia remains as an AML, NOS subtype and is now the only type of acute erythroid leukemia
MYELOID SARCOMA • Myeloid sarcoma remains in the classification as a unique clinical presentation of any subtype of AML. • Myeloid sarcoma may present de novo, may accompany PB and marrow involvement, may present as relapse of AML, or may present as progression of a prior MDS, MPN, or MDS/MPN. • Although listed separately in the classification, cases of myeloid sarcoma without evidence of marrow disease should be investigated comprehensively so that they can be classified into a more specific AML subtype
MYELOID PROLIFERATIONS OF DOWN SYNDROME • The myeloid proliferations of Down syndrome include transient abnormal myelopoiesis (TAM) and myeloid leukemia associated with Down syndrome. • Both are usually megakaryoblastic proliferations, with TAM occurring at birth or within days of birth and resolving in 1 to 2 months and myeloid leukemia occurring later, but usually in the first 3 years of life with or without prior TAM and persisting if not treated. • The myeloid neoplasms of Down syndrome have a similar behavior that is independent of blast cell count and these are not subclassified into MDS or AML. • Both TAM and myeloid leukemia associated with Down syndrome are characterized by GATA 1 mutations and mutations of the JAK-STAT pathway, with additional mutations identified in the myeloid leukemia cases.
SINGLE GENE MUTATIONS • Testing of a number of single genes has been incorporated to further risk-stratify patients, thus providing useful data for therapeutic decisions for the patients with AML with intermediate-risk based on cytogenetics. • Testing for these mutations allows reduction of the number of patients in the clinically heterogeneous intermediate-risk subgroup (Figure 2). • The currently most important genes to evaluate include the nucleolar protein nucleophosmin (NPM 1), CCAAT/ enhancer-binding protein a (CEBPA), and fmsrelated tyrosine kinase 3 (FLT 3). • In addition, mutations of the vkit Hardy-Zuckerman 4 feline sarcoma viral oncogene homolog (KIT) modify the prognosis of otherwise favorable- risk CBF AML.
• Mutations in NPM 1 are involved in 25% to 35% of patients with AML and 45% to 64% of patients with AML with normal cytogenetics. • The prognostic importance of an NPM 1 mutation is dependent upon the mutational status of a second gene, FLT 3.
• Internal tandem duplication (ITD) mutations of FLT 3 are present in approximately 20% of patients with AML, in 28% to 34% of patients with AML with normal cytogenetics, and in 40% of patients with AML with concurrent NPM 1 mutation. • The presence of a FLT 3 - ITD confers an adverse prognosis for those with intermediate- risk cytogenetics and for patients with NPM 1 mutations, • So testing of these 2 genes must be performed together to provide accurate prognostic information.
• In the absence of FLT 3 -ITD mutation, an NPM 1 mutation confers a favorable prognosis for those with normal cytogenetics. • Though HSCT is effective in patients with a normal karyotype and NPM 1+/FLT 3 ITD genotype, retrospective analysis suggests the benefits of HSCT do not outweigh its associated significant morbidity and mortality in this population, while HSCT should be considered at first remission in other genotypes. • Recent studies have suggested that HSCT could still be considered in this population; however, patients with NPM 1 mutations are often able to have effective salvage treatment at relapse, and in general HSCT is initially withheld in this cohort.
• Mutations in CEBPA are present in 10% to 18% of patients with AML with normal cytogenetics. Whereas a single mutation in CEBPA does not affect prognosis, biallelic mutations confer a favorable prognosis, constitute another provisional WHO AML subtype, and direct consolidative chemotherapy rather than HCST at remission. • Mutations in KIT occur in 20% to 30% of CBF AML cases, which is typically considered to be favorable-risk. However, the presence of KIT mutations confers an increased risk of relapse • Therefore, CBF AML with KIT mutations is considered to be at intermediate-risk in the most recent National Comprehensive Cancer Network guidelines.
• Very often, studies exhibit contradictory results regarding the prognostic significance of individual genes. The IDH genes and DNMT 3 A are relevant examples of this phenomenon • The bulk of the current evidence would suggest that IDH 1 mutations are associated with a somewhat worse prognosis, while IDH 2 mutant effects are codon-dependent
• Another factor that appears to be important in AML prognostication is the allele burden of the mutation in question. • It is well established that AML specimens contain multiple disease clones at diagnosis, and mutations in signaling genes, such as FLT 3 and KIT, are frequently present in only a subset of the malignant blasts at diagnosis. • Therefore, it is plausible that a FLT 3 -ITD mutation present in a small minority of the malignant blasts may not be as prognostically significant as that present in the entirety of the blast population. • Indeed, this seems to be the case, as the adverse effect of FLT 3 -ITD mutations on cytogenetically normal AML appears to increase with increasing allele burden
• In some cases of FLT 3 -ITD–positive AML, the mutant allele to wild-type FLT 3 ratio is actually greater than 0. 5, indicative of loss of heterozygosity at the FLT 3 locus, often secondary to duplication of the mutant FLT 3 allele. These cases may have a particularly poor prognosis. • However, not all studies have confirmed a strong correlation between prognosis and allelic burden, and some recent data suggest that even low-level FLT 3 -ITD mutant clones at diagnosis may indicate aggressive disease, which would be consistent with the concept that these subclones may be especially chemoresistant • Recently, investigations into the clinical relevance of WT 1 mutations demonstrated that they were found in 12% of diagnostic pediatric AML samples. • These mutations were associated with a normal karyotype (22 %) and FLT 3/ITD, and were found to be an independent poor prognostic factor.
• Metaphase karyotyping is absolutely necessary, and for those patients with intermediate-risk cytogenetics, molecular assessment of FLT 3, NPM 1, and CEBPA should be performed. • If the patient is found to have CBF AML, KIT should be assessed for mutations
REFERENCES • 1. Bennett JM, Catovsky D, Daniel MT, et al. Proposals for the classification of the acute leukaemias: French-American-British (FAB) co-operative group. Br J Haematol. 1976; 33(4): 451– 458. • 2. Speck NA, Gilliland DG. Core-binding factors in haematopoiesis and leukaemia. Nat Rev Cancer. 2002; 2(7): 502– 513. • 3. Balgobind BV, Raimondi SC, Harbott J, et al. Novel prognostic subgroups in childhood 11 q 23/MLL-rearranged acute myeloid leukemia: results of an international retrospective study. Blood. 2009; 114(12): 2489– 2496. • 4. Grimwade D, Hills RK, Moorman AV, et al. Refinement of cytogenetic classification in acute myeloid leukemia: determination of prognostic significance of rare recurring chromosomal abnormalities among 5876 younger adult patients treated in the United Kingdom Medical Research Council trials. Blood. 2010; 116(3): 354– 365.
• 5. Krauth M-T, Eder C, Alpermann T, et al. High number of additional genetic lesions in acute myeloid leukemia with t(8; 21)/RUNX 1 -RUNX 1 T 1: frequency and impact on clinical outcome. Leukemia. 2014; 28(7): 1449– 1458. • 6. Kottaridis PD, Gale RE, Langabeer SE, Frew ME, Bowen DT, Linch DC. Studies of FLT 3 mutations in paired presentation and relapse samples from patients with acute myeloid leukemia: implications for the role of FLT 3 mutations in leukemogenesis, minimal residual disease detection, and possible therapy with FLT 3 inhibitors. Blood. 2002; 100(7): 2393– 2398. • 7. Stein EM, Altman JK, Collins R, et al. AG-221, an oral, selective, first-inclass, potent inhibitor of the IDH 2 mutant metabolic enzyme, induces durable remissions in a phase I study in patients with IDH 2 mutation positive advanced hematologic malignancies. Blood. 2014; 124(21): 115
• 8. Linch DC, Hills RK, Burnett AK, Khwaja A, Gale RE. Impact of FLT 3 ITD mutant allele level on relapse risk in intermediate-risk acute myeloid leukemia. Blood. 2014; 124(2): 273– 276. • 9. Hirsch P, Labopin M, Marzac C, et al. Impact of FLT 3 -ITD mutational burden in 469 acute myeloid leukemia (AML) patients. Blood. 2014; 124(21): 1033– 1033. • 10. Allen C, Hills RK, Lamb K, et al. The importance of relative mutant level for evaluating impact on outcome of KIT, FLT 3 and CBL mutations in core-binding factor acute myeloid leukemia. Leukemia. 2013; 27(9): 1891– 1901. • 11. Sehgal AR, Gimotty PA, Zhao J, et al. DNMT 3 A mutational status affects the results of dose-escalated induction therapy in acute myelogenous leukemia. Clin Cancer Res. 2015; 21(7): 1614– 1620.
• 12. Gale RE, Green C, Allen C, et al. The impact of FLT 3 internal tandem duplication mutant level, number, size, and interaction with NPM 1 mutations in a large cohort of young adult patients with acute myeloid leukemia. Blood. 2008; 111(5): 2776– 2784. • 13. Michael L. Wang, MD, Ph. D; Nathanael G. Bailey, MD. Acute Myeloid Leukemia Genetics, Risk Stratification and Implications for Therapy. Arch Pathol Lab Med. 2015; 139: 12151223 • 14. Daniel A. Arber, 1 Attilio Orazi, 2 Robert Hasserjian, et al. The 2016 revision to the World Health Organization classification of myeloid neoplasms and acute leukemia. BLOOD, . 2016; 127: 2391 -2405 • 15. Hartmut D¨ohner, 1 Elihu Estey, et al. David Grimwade, . Diagnosis and management of AML in adults: 2017 ELN recommendations from an international expert panel. BLOOD, 2017; 129; 424 -447